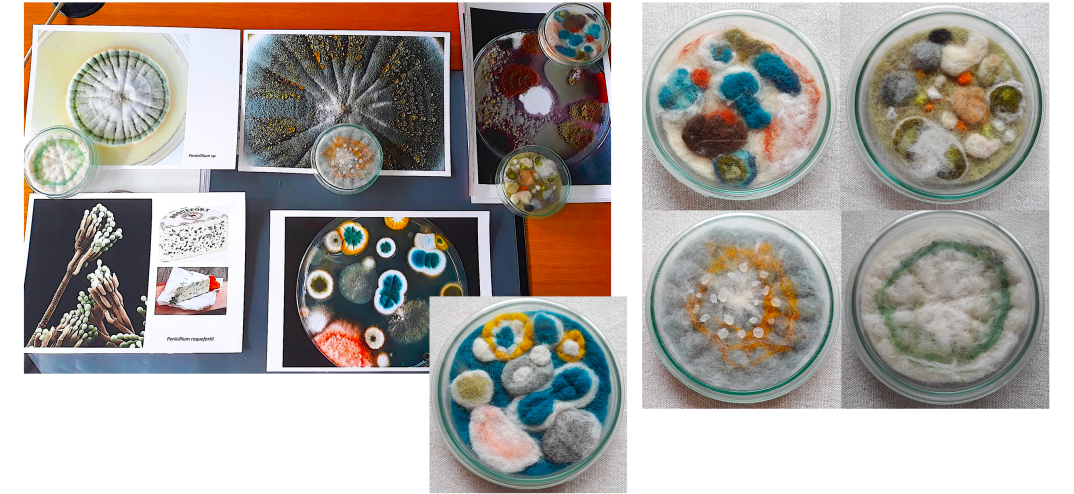
Screenshot 2018-11-02 16.24.16.png

Criamos diversos modelos em croché (e outras técnicas) que usamos nas nossas exposições, oficinas e outras acções de comunicação de ciência como se pode ver no separador ACTIVIDADES. No caso de haver interesse poderão ser produzidas réplicas por encomenda (valores e tempos de entrega sob consulta enviando email para stol@bio.uminho.pt).
COGUMELOS


CAIXAS DE PETRI COM COLÓNIAS DE BOLORES
LÍQUENES

CÉREBRO HUMANO

CAIXA DE SUPERFÍCIES HIPERBÓLICAS
